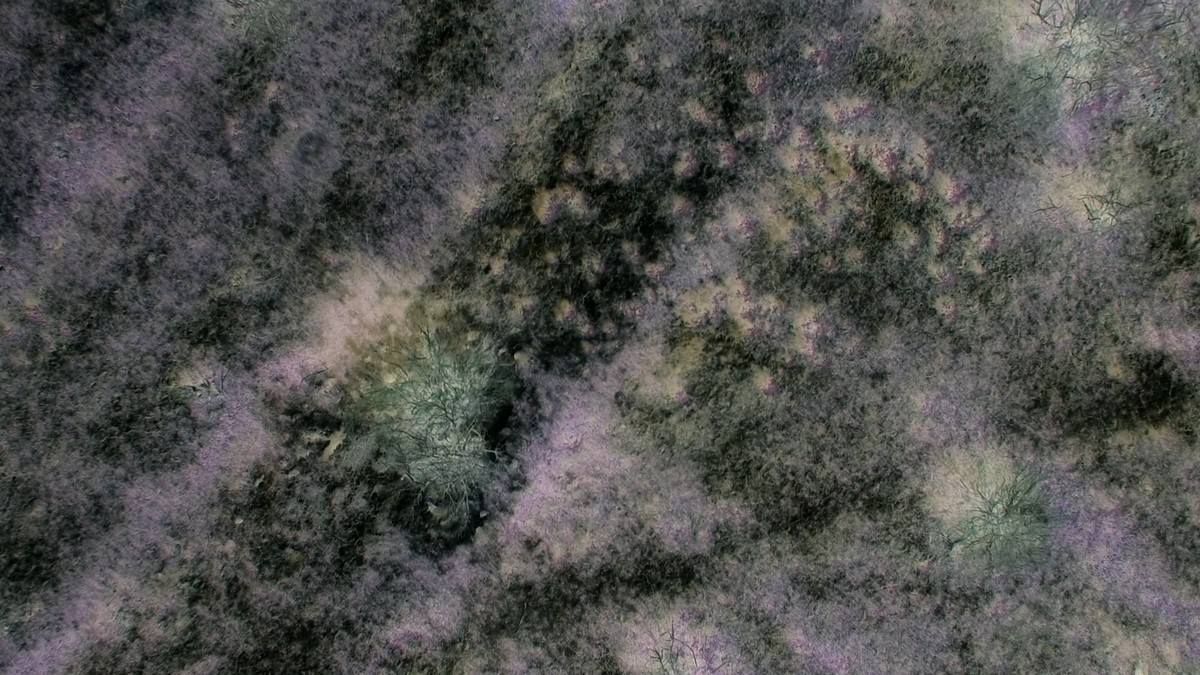
Two horizons

Saodat Ismaïlova
Two horizons - Installation - 2017
présentée dans le cadre de l'exposition panorama 19 - Roman



Two Horizons is a two screen video installation that speculates between an ancient Turkic myth of the Eurasian steppes – Qorqut, the First Shaman who had lost gravity and a soviet space travel by the first human – Yuri Gagarin, Vostok 1 mission, 1961. The cemetery of Qorqut and the Baikanur space station are both situated in the south of Kazakhstan in a distance of 20 kilometers. Locals believe that human space travel was predicted to be next to the ancient grave of Qorqut. Both the ancient myth and the soviet exploration are bound by a final human search of immortality. Two Horizons pretends to capture the place and sound of the geographic point where the first and last human levitated suspended in time.
Born in 1981 in Tashkent, soviet Uzbekistan, graduated from Tashkent State Art Institute (Uzbekistan). Her art work is devoted to bring to surface Central Asia’s soul by creating modern myths catapulted with the recent past of the region. While inspired by old myths and beliefs, she builds bridges between past and present, retracing back a spiritual past that is fading, sewing back forgotten and recollected stories of parallel visions between imaginary, mythical characters and concrete historical figures as well as translating these stories into modern audiovisual art projects with a stress on the female world. Saodat Ismailova comes from a documentary and narrative cinema background and now works in audiovisual art forms, often referring to archives and anthropology. Saodat Ismailova participated with her work in the Cannes Film Festival, the Berlinale, the Berlin International Film Festival, the Venice Art Biennale, the Edinburgh, and the Seattle International Film Festivals, among many others. She is currently working in Tashkent, Uzbekistan, and in France, where she is a student at Le Fresnoy - Studio national des arts contemporains.